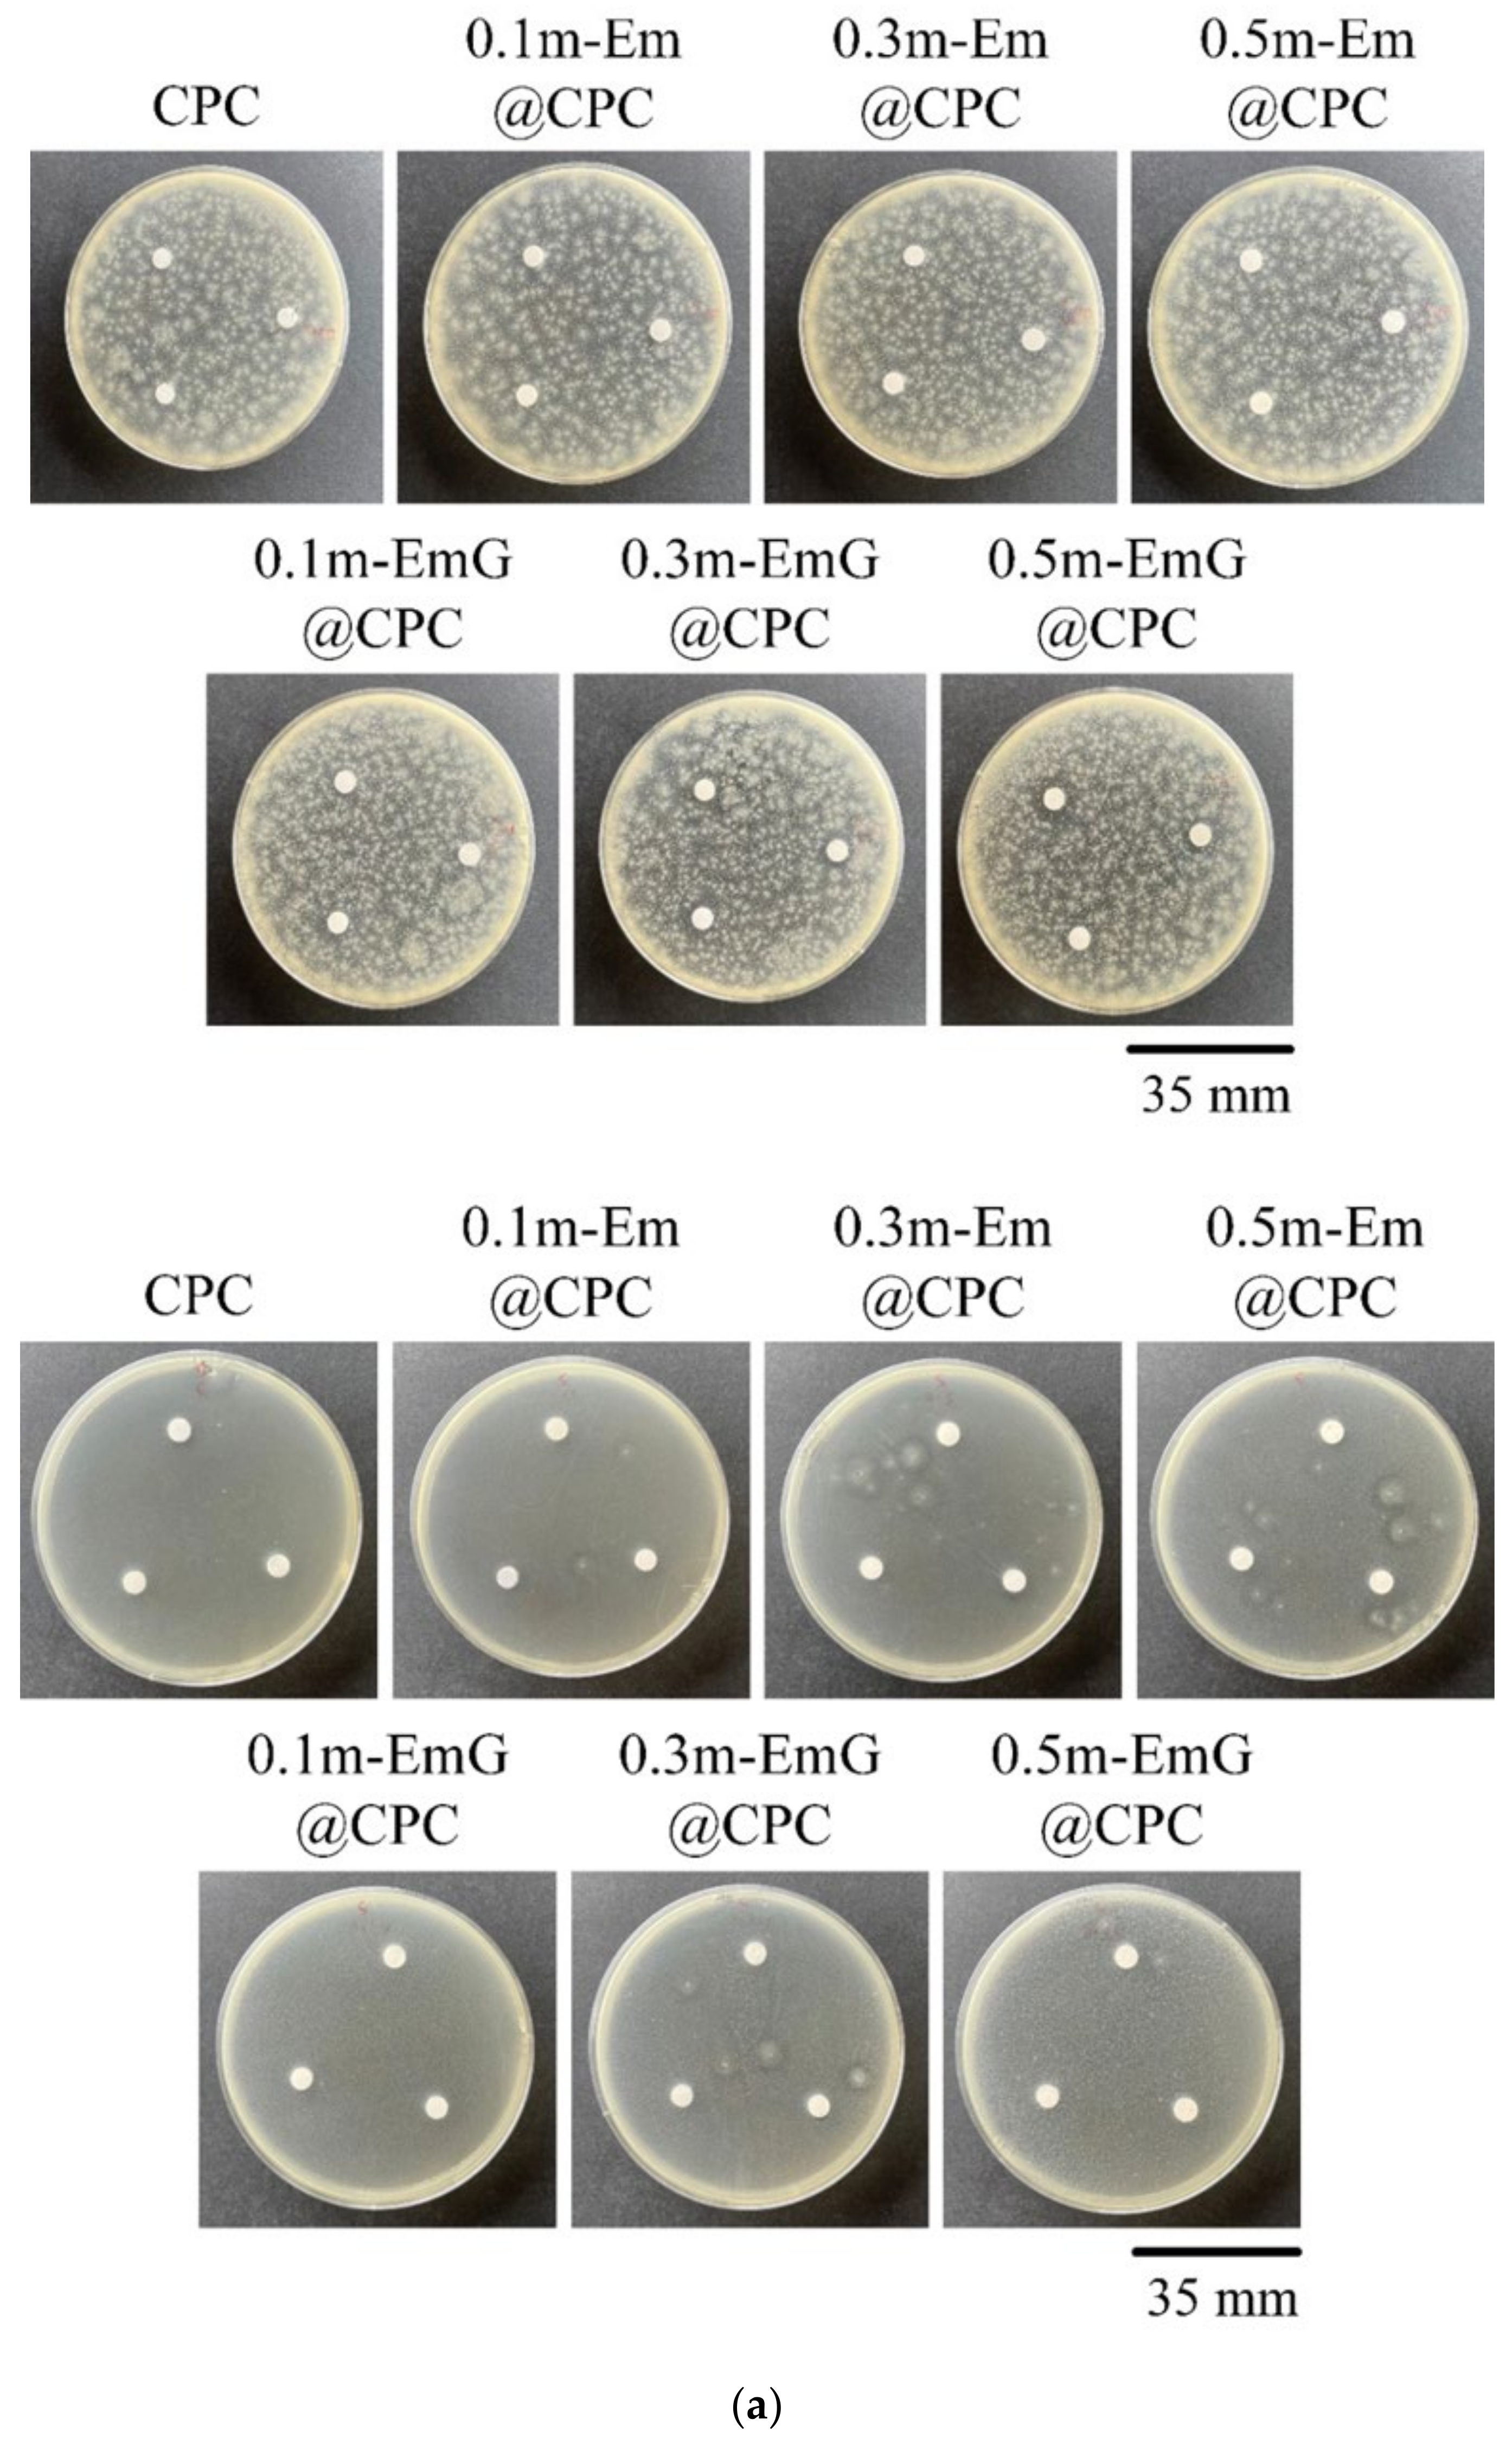

Mechanical Properties, Drug Release, Biocompatibility, and Antibacterial Activities of Modified Emulsified Gelatin Microsphere Loaded with Gentamicin Composite Calcium Phosphate Bone Cement In Vitro
Abstract
1. Introduction
2. Materials and Methods
2.1. Raw Materials
2.2. Preparation of Gel Microspheres (Em, m-Em, and m-EmG) and CPC Composites (m-Em@CPC and m-EmG@CPC)
2.2.1. Emulsified Gel Microspheres (Em)
2.2.2. Em Modification (m-Em) and Antibiotic Impregnation (m-EmG)
2.2.3. m-EmG Composite CPC Process
2.3. Physiochemical Properties
2.3.1. Microstructure Observations
2.3.2. Spectral Analysis by Fourier Transform Infrared Spectroscopy (FTIR)
2.3.3. Changes in Immersion Weight of Hydrogel Microspheres
2.3.4. Crosslinking Index Changes
2.3.5. Thermal Stability
2.3.6. Gentamicin Release
2.3.7. Phase Identification
2.3.8. Working/Setting Time Measurements
2.3.9. Injectability and Disintegration
2.3.10. Compressive Strength and Fracture Surface Observation
2.4. Antibacterial Tests
2.4.1. Qualitative Antibacterial Testing
2.4.2. Quantitative Antibacterial Testing
2.5. In Vitro Cytotoxicity and Osteoprogenitor Cell Activities
2.5.1. Cell Culture
2.5.2. Cytotoxicity Tests
2.5.3. D1 Cell Proliferation, Mineralization, and ALP Staining
2.6. Statistical Analysis
3. Results and Discussion
3.1. Analysis of Different Gel Microspheres
3.1.1. Observation of Em, mEm, and m-EmG Microspheres
3.1.2. Absorption IR Spectra
3.1.3. Degradation Measurement of Em and m-Em
3.1.4. TGA and DSC Analysis of m-Em and m-EmG
3.1.5. Antibiotic Release of m-EmG
3.1.6. Antibacterial Efficiency of m-EmG
3.1.7. Biocompatibilities of Em, m-Em, and m-EmG
3.2. Characterizations of m-EmG@CPC Composites
3.2.1. IR Spectra of Different Microsphere Ratios of m-EmG@CPC Composites
3.2.2. Diffraction Patterns of m-EmG@CPC Composites
3.2.3. Injectability and Disintegration of m-EmG@CPC Composites
3.2.4. Compressive Strength and Fractural Surface Observation of m-EmG@CPC Composites
3.2.5. Qualitative and Quantitative Antibacterial Testing
3.2.6. Gentamicin Release of 0.5m-EmG@CPC Composite
3.2.7. Working/Setting Times
3.3. In Vitro Cytotoxicity and D1 Cell Interactions
3.3.1. Cytotoxicity
3.3.2. Osteoprogenitor-D1 Cell Proliferation and Mineralization
4. Conclusions
Author Contributions
Funding
Institutional Review Board Statement
Informed Consent Statement
Data Availability Statement
Acknowledgments
Conflicts of Interest
References
- Ginebra, M.-P.; Canal, C.; Espanol, M.; Pastorino, D.; Montufar, E.B. Calcium phosphate cements as drug delivery materials. Adv. Drug Deliv. Rev. 2012, 64, 1090–1110. [Google Scholar] [CrossRef] [PubMed]
- Kurashina, K.; Ogiso, A.; Kotani, A.; Takeuchi, H.; Hirano, M. Histological and microradiographic evaluation of hydrated and hardened α-tricalcium phosphate/calcium phosphate dibasic mixtures. Biomaterials 1994, 15, 429–432. [Google Scholar] [CrossRef]
- Apelt, D.; Theiss, F.; El-Warrak, A.O.; Zlinszky, K.; Bettschart-Wolfisberger, R.; Bohner, M.; Matter, S.; Auer, J.A.; von Rechenberg, B. In vivo behavior of three different injectable hydraulic calcium phosphate cements. Biomaterials 2004, 25, 1439–1451. [Google Scholar] [CrossRef] [PubMed]
- Li, C.; Lv, H.; Du, Y.; Zhu, W.; Yang, W.; Wang, X.; Wang, J.; Chen, W. Biologically modified implantation as therapeutic bioabsorbable materials for bone defect repair. Regen. Ther. 2022, 19, 9–23. [Google Scholar] [CrossRef] [PubMed]
- Wang, P.; Wang, X. Mimicking the native bone regenerative microenvironment for in situ repair of large physiological and pathological bone defects. Eng. Regen. 2022, 3, 440–452. [Google Scholar] [CrossRef]
- Zhang, J.; Jiang, Y.; Shang, Z.; Zhao, B.; Jiao, M.; Liu, W.; Cheng, M.; Zhai, B.; Guo, Y.; Liu, B.; et al. Biodegradable metals for bone defect repair: A systematic review and meta-analysis based on animal studies. Bioact. Mater. 2021, 6, 4027–4052. [Google Scholar] [CrossRef] [PubMed]
- Zhang, L.; Yang, G.; Johnson, B.N.; Jia, X. Three-dimensional (3D) printed scaffold and material selection for bone repair. Acta Biomater. 2019, 84, 16–33. [Google Scholar] [CrossRef] [PubMed]
- Chohayeb, A.A.; Chow, L.C.; Tsaknis, P.J. Evaluation of calcium phosphate as a root canal sealer-filler material. J. Endod. 1987, 13, 384–387. [Google Scholar] [CrossRef] [PubMed]
- Chow, L.C. Development of self-setting calcium phosphate cements. J. Ceram. Soc. Jpn. 1991, 99, 954–964. [Google Scholar] [CrossRef]
- Costantino, P.D.; Friedman, C.D.; Jones, K.; Chow, L.C.; Pelzer, H.J.; Sisson, G.A., Sr. Hydroxyapatite Cement: I. Basic Chemistry and Histologic Properties. Arch. Otolaryngol. Head Neck Surg. 1991, 117, 379–384. [Google Scholar] [CrossRef]
- Ewald, A.; Fuchs, A.; Boegelein, L.; Grunz, J.-P.; Kneist, K.; Gbureck, U.; Hoelscher-Doht, S. Degradation and Bone-Contact Biocompatibility of Two Drillable Magnesium Phosphate Bone Cements in an In Vivo Rabbit Bone Defect Model. Materials 2023, 16, 4650. [Google Scholar] [CrossRef] [PubMed]
- Sasaki, K.; Ninomiya, Y.; Takechi, M.; Tsuru, K.; Ishikawa, K.; Shigeishi, H.; Ohta, K.; Aikawa, T. Physical Properties and Antimicrobial Release Ability of Gentamicin-Loaded Apatite Cement/α-TCP Composites: An In Vitro Study. Materials 2023, 16, 995. [Google Scholar] [CrossRef] [PubMed]
- Cho, E.; Kim, J.E.; Lee, J.; Park, S.; Lee, S.; Chung, J.H.; Kim, J.; Seonwoo, H. Development of 3D Printable Calcium Phosphate Cement Scaffolds with Cockle Shell Powders. Materials 2023, 16, 6154. [Google Scholar] [CrossRef] [PubMed]
- Feldman, G.; Young, D.; Freeman, T.; Israel, L.; Taub, D.; Diecidue, R. Geranylgeraniol (GGOH), incorporated into a bone cement pellet promotes osteoclast function and healing in a model of medication-related osteonecrosis of the jaw. J. Oral Biol. Craniofac. Res. 2024, 14, 126–132. [Google Scholar] [CrossRef]
- Liu, S.-M.; Chen, J.-C.; Huang, S.-M.; Lin, S.-H.; Chen, W.-C. Enhanced Cell Osteogenic Differentiation in Alendronate Acid and Flufenamic Acid Drug-Impregnated Nanoparticles of Mesoporous Bioactive Glass Composite Calcium Phosphate Bone Cement In Vitro. Pharmaceuticals 2023, 16, 680. [Google Scholar] [CrossRef]
- Huang, S.-M.; Chen, W.-C.; Wu, C.-C.; Liu, S.-M.; Ko, C.-L.; Chen, J.-C.; Shih, C.-J. Synergistic effect of drug/antibiotic-impregnated micro/nanohybrid mesoporous bioactive glass/calcium phosphate composite bone cement on antibacterial and osteoconductive activities. Biomater. Adv. 2023, 152, 213524. [Google Scholar] [CrossRef] [PubMed]
- Jaberifard, F.; Arsalani, N.; Ghorbani, M.; Mostafavi, H. Incorporating halloysite nanotube/carvedilol nanohybrids into gelatin microsphere as a novel oral pH-sensitive drug delivery system. Colloids Surf. A Physicochem. Eng. Asp. 2022, 637, 128122. [Google Scholar] [CrossRef]
- Moura, M.J.; Gil, M.H.; Figueiredo, M.M. Cisplatin delivery systems based on different drug encapsulation techniques. Eur. Polym. J. 2019, 113, 357–364. [Google Scholar] [CrossRef]
- Dong, Q.; Chen, S.; Zhou, J.; Liu, J.; Zou, Y.; Lin, J.; Yao, J.; Cai, D.; Tao, D.; Wu, B.; et al. Design of functional vancomycin-embedded bio-derived extracellular matrix hydrogels for repairing infectious bone defects. Nanotechnol. Rev. 2023, 12, 20220524. [Google Scholar] [CrossRef]
- Choi, M.J.; Briançon, S.; Andrieu, J.; Min, S.G.; Fessi, H. Effect of Freeze-Drying Process Conditions on the Stability of Nanoparticles. Dry. Technol. 2004, 22, 335–346. [Google Scholar] [CrossRef]
- Dong, Z.; Meng, X.; Yang, W.; Zhang, J.; Sun, P.; Zhang, H.; Fang, X.; Wang, D.-A.; Fan, C. Progress of gelatin-based microspheres (GMSs) as delivery vehicles of drug and cell. Mater. Sci. Eng. C 2021, 122, 111949. [Google Scholar] [CrossRef] [PubMed]
- Cai, R.; Gimenez-Camino, N.; Xiao, M.; Bi, S.; DiVito, K.A. Technological advances in three-dimensional skin tissue engineering. Rev. Adv. Mater. Sci. 2023, 62, 20220289. [Google Scholar] [CrossRef]
- Li, L.; Du, Y.; Yin, Z.; Li, L.; Peng, H.; Zheng, H.; Yang, A.; Li, H.; Lv, G. Preparation and the hemostatic property study of porous gelatin microspheres both in vitro and in vivo. Colloids Surf. B 2020, 187, 110641. [Google Scholar] [CrossRef] [PubMed]
- Sionkowska, A. Collagen blended with natural polymers: Recent advances and trends. Prog. Polym. Sci. 2021, 122, 101452. [Google Scholar] [CrossRef]
- Uyen, N.T.T.; Hamid, Z.A.A.; Tram, N.X.T.; Ahmad, N. Fabrication of alginate microspheres for drug delivery: A review. Int. J. Biol. Macromol. 2020, 153, 1035–1046. [Google Scholar] [CrossRef] [PubMed]
- Alves, A.A.S.; Cruz, P.F.; Brito, R.M.M.; Feitosa, E.; Antunes, F.E. Development of sugar based biodegradable nanoencapsulators: Understanding the role of the alcohol injection method on the preparation of aqueous dispersions of sorbitan ester vesicles. J. Mol. Liq. 2019, 277, 481–489. [Google Scholar] [CrossRef]
- Chen, C.; Chen, Y.; Wu, P.; Chen, B. Update on new medicinal applications of gentamicin: Evidence-based review. J. Formos. Med. Assoc. 2014, 113, 72–82. [Google Scholar] [CrossRef] [PubMed]
- Li, X.; Xu, D.; Yang, J.; Yan, Z.; Luo, T.; Li, X.; Zhang, Z.; Wang, X. Utilization of FBRM and PVM to analyze the effects of different additives on the crystallization of ammonium dihydrogen phosphate. J. Cryst. Growth 2021, 576, 126378. [Google Scholar] [CrossRef]
- Al Thaher, Y. Tailored gentamicin release from silica nanocarriers coated with polyelectrolyte multilayers. Colloids Surf. A Physicochem. Eng. Asp. 2021, 614, 126210. [Google Scholar] [CrossRef]
- Ko, C.-L.; Chen, J.-C.; Hung, C.-C.; Wang, J.-C.; Tien, Y.-C.; Chen, W.-C. Biphasic products of dicalcium phosphate-rich cement with injectability and nondispersibility. Mater. Sci. Eng. C 2014, 39, 40–46. [Google Scholar] [CrossRef]
- Sung, H.-W.; Chang, Y.; Chiu, Y.-T.; Hsu, H.-L.; Shih, C.-C.; Lu, J.-H.; Yang, P.-C. Evaluation of an epoxy-fixed biological patch with ionically bound heparin as a pericardial substitute. Biomaterials 1996, 17, 1693–1701. [Google Scholar] [CrossRef] [PubMed]
- ISO 9917-1: 2007; Dentistry—Water Based Cements Part 1: Powder/Liquid. International Organization for Standardization: Geneva, Switzerland, 2007.
- ASTM F451-16; Standard Specification for Acrylic Bone Cement. ASTM International: West Conshohocken, PA, USA, 2019.
- ISO 10993-5:2009; Biological Evaluation of Medical Devices—Part 5: Tests for In Vitro Cytotoxicity. International Organization for Standardization: Geneve, Switzerland, 2009.
- Loyo, C.; Palza, H.; Saavedra, M.; Canales, D.; García-Herrera, C.; Olate-Moya, F.; Melo, F.; Cordova, L.; Solano, L.; Zapata, P.A. Electrospun polycaprolactone/graphene oxide scaffolds with secondary surface porosity and gelatin-coating. Mater. Today Commun. 2024, 39, 109057. [Google Scholar] [CrossRef]
- Lodoso-Torrecilla, I.; Stumpel, F.; Jansen, J.A.; van den Beucken, J.J.J.P. Early-stage macroporosity enhancement in calcium phosphate cements by inclusion of poly(N-vinylpyrrolidone) particles as a porogen. Mater. Today Commun. 2020, 23, 100901. [Google Scholar] [CrossRef]
- Marinozzi, F.; Bini, F.; Marinozzi, A. Evidence of entropic elasticity of human bone trabeculae at low strains. J. Biomech. 2011, 44, 988–991. [Google Scholar] [CrossRef]
- Tian, K.V.; Nagy, P.M.; Chass, G.A.; Fejerdy, P.; Nicholson, J.W.; Csizmadia, I.G.; Dobó-Nagy, C. Qualitative assessment of microstructure and Hertzian indentation failure in biocompatible glass ionomer cements. J. Mater. Sci. Mater. Med. 2012, 23, 677–685. [Google Scholar] [CrossRef]

| Samples | Working Time (min) | Setting Time (min) |
|---|---|---|
| CPC | 5.18 ± 0.09 | 10.26 ± 0.12 |
| 0.5m-Em@CPC | 5.24 ± 0.08 | 10.29 ± 0.03 |
| 0.5m-EmG@CPC | 5.24 ± 0.09 | 10.30 ± 0.07 |
Disclaimer/Publisher’s Note: The statements, opinions and data contained in all publications are solely those of the individual author(s) and contributor(s) and not of MDPI and/or the editor(s). MDPI and/or the editor(s) disclaim responsibility for any injury to people or property resulting from any ideas, methods, instructions or products referred to in the content. |
© 2024 by the authors. Licensee MDPI, Basel, Switzerland. This article is an open access article distributed under the terms and conditions of the Creative Commons Attribution (CC BY) license (https://creativecommons.org/licenses/by/4.0/).
Share and Cite
Hu, M.-H.; Shih, B.-S.; Liu, S.-M.; Huang, S.-M.; Ko, C.-L.; Chen, W.-C. Mechanical Properties, Drug Release, Biocompatibility, and Antibacterial Activities of Modified Emulsified Gelatin Microsphere Loaded with Gentamicin Composite Calcium Phosphate Bone Cement In Vitro. Materials 2024, 17, 3578. https://doi.org/10.3390/ma17143578
Hu M-H, Shih B-S, Liu S-M, Huang S-M, Ko C-L, Chen W-C. Mechanical Properties, Drug Release, Biocompatibility, and Antibacterial Activities of Modified Emulsified Gelatin Microsphere Loaded with Gentamicin Composite Calcium Phosphate Bone Cement In Vitro. Materials. 2024; 17(14):3578. https://doi.org/10.3390/ma17143578
Chicago/Turabian StyleHu, Ming-Hsien, Bo-Sin Shih, Shih-Ming Liu, Ssu-Meng Huang, Chia-Ling Ko, and Wen-Cheng Chen. 2024. "Mechanical Properties, Drug Release, Biocompatibility, and Antibacterial Activities of Modified Emulsified Gelatin Microsphere Loaded with Gentamicin Composite Calcium Phosphate Bone Cement In Vitro" Materials 17, no. 14: 3578. https://doi.org/10.3390/ma17143578
APA StyleHu, M.-H., Shih, B.-S., Liu, S.-M., Huang, S.-M., Ko, C.-L., & Chen, W.-C. (2024). Mechanical Properties, Drug Release, Biocompatibility, and Antibacterial Activities of Modified Emulsified Gelatin Microsphere Loaded with Gentamicin Composite Calcium Phosphate Bone Cement In Vitro. Materials, 17(14), 3578. https://doi.org/10.3390/ma17143578

